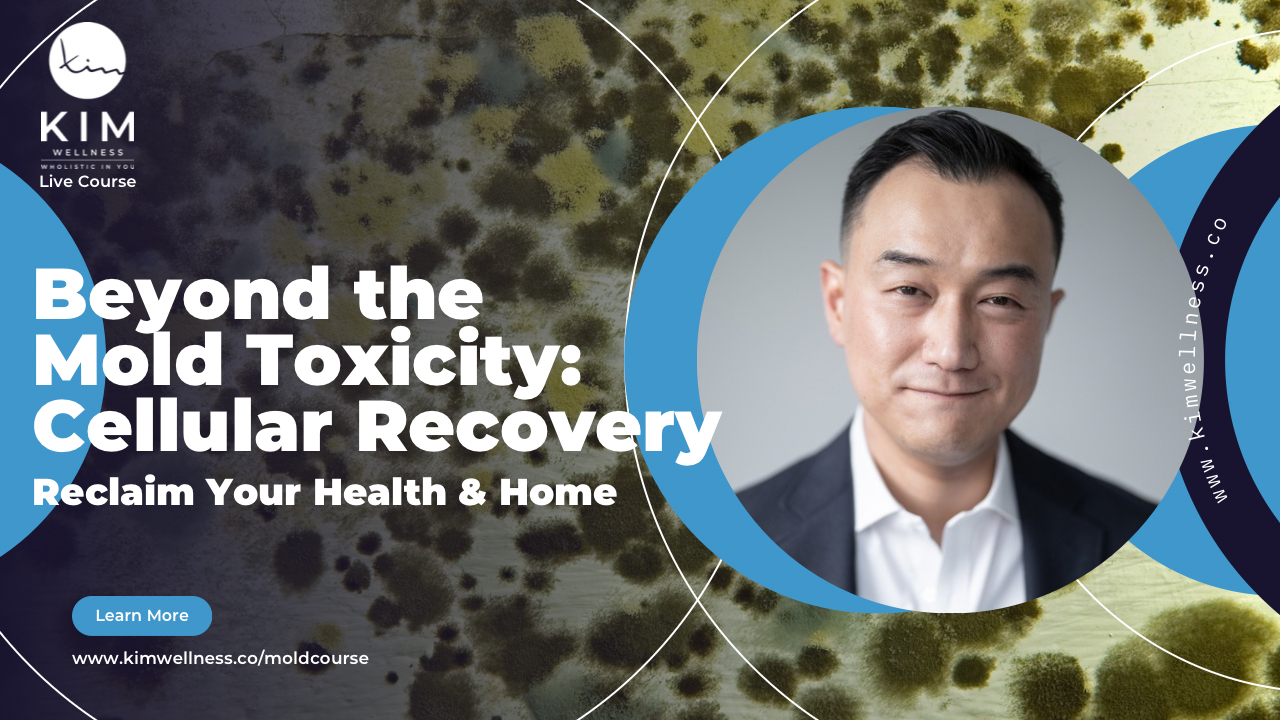

Beyond the
Mold Toxicity: Cellular Recovery
Reclaim Your Health & Home
(Self- Paced)

I am so thankful to God for Dr. Kim's help. I was struggling everyday with POTS, hypothyroidism, anxiety, and gut issues. I did not feel myself or able to keep up with life. It was especially discouraging trying to care for my 3 year old son. Dr. Kim's assessments, testing, and protocols are thorough unlike other providers I've seen. He was very generous with his time for all my questions and concerns. We found my root issues including mold toxicity, adrenal fatigue, nervous system dysregulation, SIBO, and parasites. I loved how he looked at my health on all levels, including lifestyle and circadian rhythm. With his guidance, I found and remediated a mold issue in my HVAC system. I could tell such a difference in how I felt afterwards! After 6 months, I am so happy to say my thyroid levels are within normal range, I am mold toxin free, and my gut functions normally! I also lost some stubborn weight, learned how to better regulate my nervous system, and regained my energy and confidence. Do not hesitate to get high quality care from Dr. Kim, you will not regret the investment!
Â
R.H. 38 Years Old Female
Is Mold Affecting Your Health?

Energy and Cognition
Mold toxins can disrupt your energy levels and cognitive function, leading to persistent fatigue and mental fog.

Respiratory Problems
Mold can trigger allergies, asthma, and other respiratory problems, causing coughing, wheezing, and difficulty breathing.

Chronic Health Issues
Mold exposure can contribute to a wide range of chronic health problems, including headaches, muscle aches, and digestive issues.
Â
INTRODUCINGÂ THE COURSE...
Beyond the Mold Toxicity: Cellular Recovery
Identify the Hidden Culprit
Uncover the often-overlooked source of your chronic health issues and learn how to test for and identify mold in your environment.
Â
Detoxify & Restore
Implement powerful detoxification strategies to eliminate mold toxins from your body and support your natural healing process.
Â
Reclaim Your Energy & Focus
Say goodbye to brain fog, fatigue, and other debilitating symptoms and regain your vitality and mental clarity.

E.I. 44 YEARS OLD
I came to Dr. Kim with some serious digestion issues. Years of being diagnosed as having "IBS" with no remedy had certainly taken its toll on me and my gut. Working with Dr. Kim has been a process of working with feedback and tests to come up with a supplement and life plan that support my digestive and overall health. We are still in the process, but l've made such staggering progress that I'm excited for the next steps in this journey. I'm very grateful for his insight and expertise, and I'm excited about the next steps in this journey!

E.M. 45 YEARS OLD
Before meeting Dr. John, I was reacting to so many things. After working with him. I found out that I had a deeper issue dealing with detoxing because of mold and heavy metals. I'm still working through my challenges but I am less reactive than before. I'm now able to enjoy my life anf not worry so much about what I may end up reacting to.
Â

L.P. 38 YEARS OLD
I went through so many protocols to deal with my mold and parasites issue for a few years. At the initial stage of my healing journey, he taught me about the importance of cell membrane health and microbiome balance. After going through his cell membrane protocol, I experienced physical spasms over my liver and gallbladder that I could see and feel. The next morning, I passed so many parasites. My body has been so locked up and after one day of his protocol, I made so much progress. Thank you.
Â
 CURRICULUM

LESSONÂ #1
- What is mold toxicity and mycotoxins
- Common symptoms and manifestations
- The hidden dangers in your environment
- Basic testing methods

LESSONÂ #2
- Identifying mold sources in your home
- Proper testing procedures
- Air quality basics
- Creating a mold-free environment

LESSONÂ #3
- Understanding cellular toxicity
- Mitochondrial dysfunction
- Oxidative stress
- Cell membrane damage

LESSONÂ #4
- Opening drainage pathways
- Liver support basics
- Lymphatic system optimization
- Proper hydration protocols

LESSONÂ #5
- The gut-mold connection
- Microbiome optimization
- Addressing fungal colonization
- Digestive support strategies

LESSONÂ #6
- Types of binders and their functions
- Proper timing and dosing
- Avoiding common mistakes
- Creating your personal binder protocol

LESSONÂ #7
- Cell membrane support
- Phospholipid therapy
- Essential fatty acids
- Mineral balance

LESSONÂ #8
- Energy production optimization
- Key supplements for mitochondrial health
- ATP production
- Addressing fatigue

LESSONÂ #9
- Balancing immune response
- Reducing inflammation
- Supporting natural immunity
- Managing autoimmune conditions

LESSONÂ #10
- Addressing brain fog
- Cognitive support protocols
- Nervous system regulation
- Sleep optimization

LESSON #11
- Endocrine system support
- Thyroid optimization
- Adrenal recovery
- Sex hormone balance

LESSONÂ #12
- Maintenance protocols
- Prevention strategies
- Creating a healthy home
- Ongoing wellness plan
WHAT YOU GET
Â
Â
12-Month Access to Recorded SessionsÂ
Watch every module at your own pace. Revisit Dr. Kim’s expert teachings anytime, with no expiration.
Â
Downloadable Worksheets & ToolsÂ
Stay on track with guided worksheets, journaling prompts, and tracking tools that support your detox journey.
Â
Comprehensive Resource LibraryÂ
Get access to curated handouts, protocols, and supplemental guides to deepen your understanding and support real change.
Â
Bonus MaterialsÂ
Enjoy recipes, checklists, and additional tools designed to make detoxing simple, approachable, and effective.
Â
Optional Community SupportÂ
Access to a private forum (optional) where past participants share insights and experiences.

About
John Kim
John Kim is a distinguished Functional Medicine practitioner whose personal battle with mold toxicity transformed him into one of the leading experts in environmental illness recovery. After his own life-changing health crisis in 2015 - a severe heart attack - Dr. Kim discovered hidden mold toxins were the root cause of his condition. Through this experience, he developed a deep understanding of environmental toxicity and its profound impact on health.
Having successfully recovered through natural protocols, John Kim now dedicates his practice to helping others overcome chronic illness through evidence-based functional medicine. As the founder of Kim Wellness, he's helped thousands of patients identify and heal from environmental toxicity, while regularly speaking at international conferences to share his expertise in treating mold-related illnesses.
"I've walked this healing journey myself, and I'm committed to helping you reclaim your health just as I did." - John Kim
ENROLL TODAY!
Everyone’s health journey is different. I'm here to guide you through yours.
14-DAY MONEY-BACK GUARANTEE
If you aren’t completely satisfied with your mold detox course experience, let us know within the first 14-days for a full refund. No questions asked.
Why should I choose this course?
How long is the course?
What are the benefits of this course?
Is this course suitable for everyone?
What is the course format?
Is this course right for me if I'm not sure I have mold exposure?
Does this program replace medical treatment?
Take control of your health. Enroll Now.
JOIN THE WAITLIST
